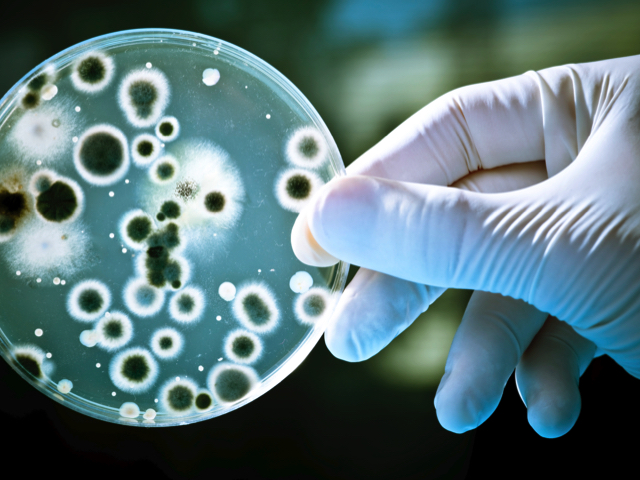

All the clothing we wear can only last a certain amount of time before it has to be cleaned in your washing machine and a new study sheds some light on how often that should be.

Is Your Laundry A Biohazard
According to a number of sources bras can be worn two to three times before they have to be washed. Jeans can too although Levi Strauss would have us believe that jeans only need washed once a year, if you like but we’re not so sure. Shirts, socks, and underwear, on the other hand, should be washed after every wear to cut down on bacteria and as we say repeatedly on here, these should be done at at least a 60˚C program for cleanliness or you can risk infections and bacteria growth, yuk.
But the new report suggest that low temperature washing doesn’t get everything out. Like, duh, we’ve said that plenty as we knew that already!
Researchers from Northumbria University have finished a study analysing molecules on our clothes that cause them to smell.
They have identified a total of six volatile organic compounds (VOCs) that make our dirty laundry smell bad, and some of them aren’t washed out during a regular cycle.
VOCs are the by-products of bacteria on our skin, such as Corynebacterium and some Staphylococcus species, that come into contact with the initially odourless sweat from our underarm.
“The need to conserve the environment by reducing the wash temperature and the use of biodegradable washing products have grown in importance in the new millennium, making this type of research more high profile,” said Professor John Dean, corresponding author of the study, in a statement.
Dean and his colleagues recruited six men and two women for their study.
After washing their feet with tap water and drying them, each participant was asked to wear a new pair of socks for at least 10 hours in a specific type of shoe. Each sock was placed in separate bags, which were stored in a dark room overnight. For the second part of the study, nine men were asked to wear a new shirt for a two- to three-hour, five-a-side soccer tournament. The shirts were bagged separately and refrigerated immediately following the tournament.
The research team washed the shirts and socks in a special washing machine made up of several smaller washing machines, called the Tergometer, at 20˚C with non-perfumed detergent.
Then they took samples of VOCs while the clothes were still wet and after they had dried.
These samples revealed evidence of six different types of VOCs with a variety of odours. Overall, the shirts and socks came out smelling a lot better than they did when they went in.
“The work is fascinating as it links an everyday event — the washing of clothes — with cutting-edge research,” said Dean. “In this particular research project we applied a new and innovative analytical technique for the detection of volatile compounds found in laundry items. We hope this provides a way of analyzing the effectiveness of different washing techniques.”
Not washing your laundry or not washing it correctly regardless of what it is can impact health in a number of ways.
Investigators from the memory-foam mattress company Ergoflex conducted a survey that gauged people’s bedtime hygiene habits. People who did not wash their pyjamas or bedsheets for more than a week were at a significantly higher risk for skin infections, drug-resistant Staph infections, and urinary tract infections.
Obviously, that’s not good.
But there you have it, (more) scientific evidence that what we’ve been telling people for years is correct.
To be serious though, these are pretty alarming results and, especially so with people washing so much of their laundry at ever lower temperatures, often with the wrong detergents, in the vain hope of saving a bit of money on their electricity bill. But in doing so may well be at risk of giving themselves or other family members a nasty infection.
How much bacteria is lurking on your clothes, bedsheets and all else?